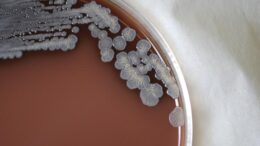

Bacteria That Causes Rare Disease Melioidosis Discovered in U.S. Environmental Samples
The Centers for Disease Control and Prevention (CDC) has identified for the first time in domestic environmental samples the bacteria that causes a rare and serious disease called melioidosis. The…